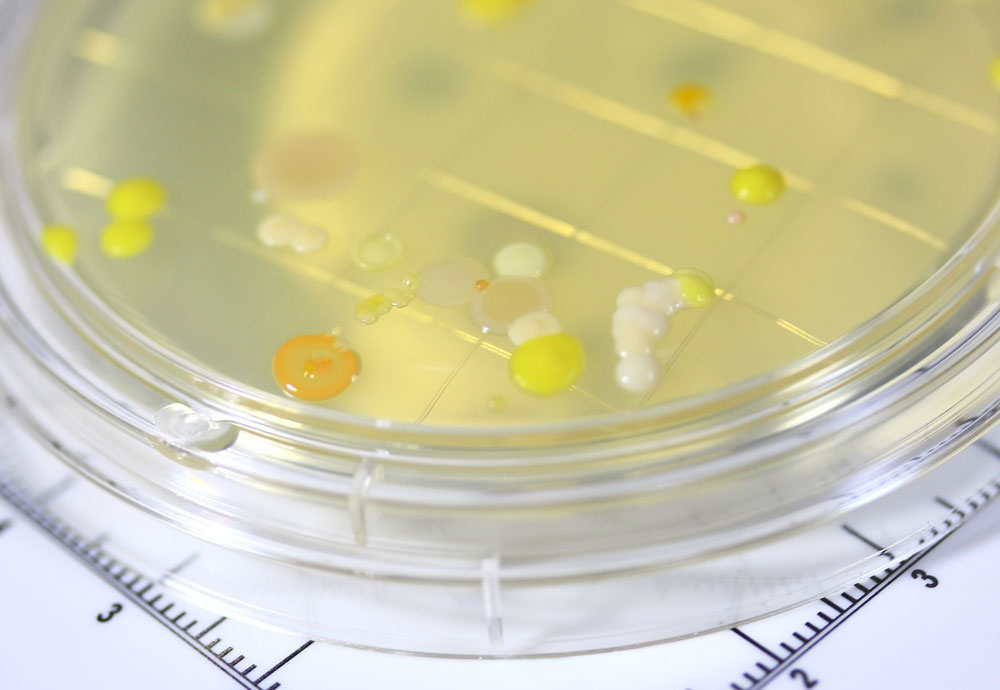

微生物検査
SERVICE

01
TESTING.01
検便検査
食品を取り扱う業務において、従業員の健康管理は欠かせません。
AKI研究所では、赤痢菌、サルモネラ属菌、腸管出血性大腸菌(Oー157など)まどを対象とした検便検査を実施。
お客様の立場に沿ったご対応に努め、検査結果は迅速にご報告いたします。
※登録衛生検査所ですので、発行する報告書は公的に有効です。

02
TESTING.02
尿検査
学校や保育施設等の集団生活いおける健康管理の一環として、尿検査は重要な役割を果たします。
AKI研究所では、糖・蛋白・潜血といった基本的な尿検査を行っております。
健康診断の一環としてもご利用いただけます。

03
TESTING.03
ノロウイルス検査
少量のウイルスでも感染力が非常に強く、不顕性感染者(自覚症状がない人)は無自覚のままウイルスを排出するため定期的な検査が必要です。AKI研究所では、リアルタイムPCR法による高感度の検査を実施しております。

04
TESTING.04
拭き取り・落下細菌検査
調理場における作業環境や器具、調理台などに付着する菌の有無を確認することで、目に見えない衛生リスクを可視化します。
AKI研究所では、拭き取り法と落下細菌法の両方に対応し、食品工場やあらゆる調理施設など多様な現場での衛生管理を強力にサポートします。